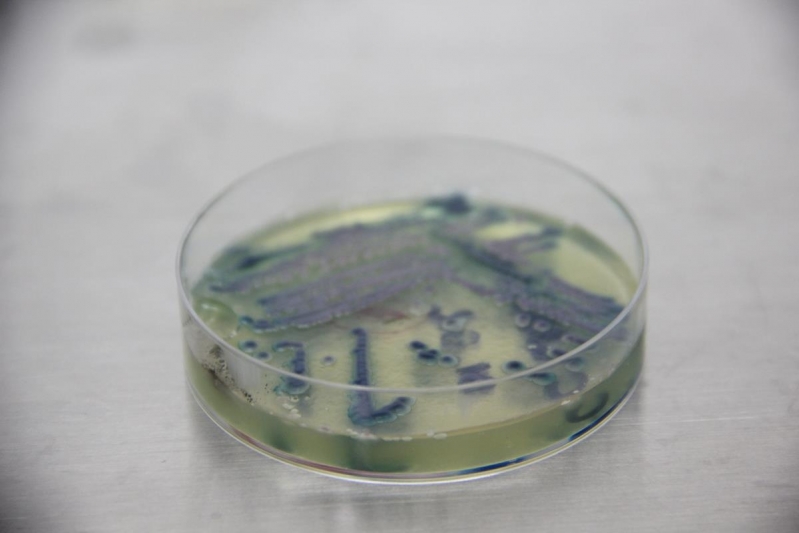

Pensando em facilitar a vida do comprador, o portal do Cotanet desenvolveu o maior número de empresas referência do ramo. Interessado por Clínica de Exame de Laboratorial em Animais Exóticos e gostaria de informações sobre o fornecedor clique em um dos fornecedores listados adiante:
 Clínicas de Exames Veterinários
Clínicas de Exames Veterinários
Clínica de Exames Laboratoriais para Animais
LABORATÓRIO CENTER VETO CenterVet se destaca como a melhor clínica de exames laboratoriais para animais de Jaguariúna, São Paulo, contando com uma equipe qualificada e competente de veterinários e patologistas. Inovação...
 Clínicas de Exames Veterinários
Clínicas de Exames Veterinários
Clínica de Exame Laboratorial Veterinário
LABORATÓRIO CENTER VETO CenterVet é uma clínica de exame laboratorial veterinário especializada, com mais de duas décadas de experiência. Qualidades da clínica de exame laboratorial veterinárioCom os mais modernos...
 Clínicas de Exames Veterinários
Clínicas de Exames Veterinários
Clínica de Exame de Leucograma Veterinária
LABORATÓRIO CENTER VETO CenterVet trabalha como clínica de exame de leucograma veterinária, uma análise de extrema autoridade para validar o estado geral de saúde de um animal e orientar tratamentos e diagnósticos....
 Clínicas de Exames Veterinários
Clínicas de Exames Veterinários
Clínica de Exame de Fibrinogênio Veterinária
LABORATÓRIO CENTER VETO CenterVet é uma clínica de exame de fibrinogênio veterinária, cumprido para avaliar proteínas sintetizadas pelo fígado. O exame é feito por profissionais patologistas experientes e visa mensurar...
 Clínicas de Exames Veterinários
Clínicas de Exames Veterinários
Clínica de Exame de Plaqueta Veterinária
LABORATÓRIO CENTER VETO CenterVet é uma clínica de exame de plaqueta veterinária. A análise de plaquetas é feita por meio do exame de sangue, no qual uma amostra do sangue do animal é coletada. Por que buscar uma...
O CenterVet é uma clínica de exame de laboratorial em animais exóticos, destinado ao atendimento especializado de proprietários de animais de estimação, zoológicos, pet shops, clínicas veterinárias, entre outros clientes que necessitam de exames de análises clínicas.
Atendimento na clínica de exame de laboratorial em animais exóticos
Todas as espécies de animais exóticos e silvestres podem passar por exames no CenterVet. A colheita das amostras e as análises são realizadas de acordo com as exigências dos pedidos do veterinário, seguindo protocolos internacionais, com máxima qualidade, segurança e precisão nos resultados. Saiba mais e entre em contato para agendar um exame.
Conheça mais sobre as outras paginas que podem lhe interessar : Clínica de Exame de Plaqueta Veterinária , Clínica de Exame de Antibiograma e Clínica de Exame de Fibrinogênio Veterinária
Cote agora mesmo com as melhores empresas
Cotar Agora Clínica de Exames Laboratoriais para Pets
Clínica de Exames Laboratoriais para Pets
Clínica de Exames Laboratoriais para Pets
LABORATÓRIO CENTER VETO CenterVet atua como clínica de exames laboratoriais para pets há mais de duas décadas, sendo considerado uma referência em exames complexos,... Cotar Agora Saiba Mais
 Clínica de Exames Laboratoriais para Cachorro
Clínica de Exames Laboratoriais para Cachorro
Clínica de Exames Laboratoriais para Cachorro
LABORATÓRIO CENTER VETNo CenterVet, proprietários de cães de todas as raças podem solicitar a realização de exames diagnósticos. A clínica de exames laboratoriais para... Cotar Agora Saiba Mais
 Clínica de Exames Laboratoriais para Animais
Clínica de Exames Laboratoriais para Animais
Clínica de Exames Laboratoriais para Animais
LABORATÓRIO CENTER VETO CenterVet se destaca como a melhor clínica de exames laboratoriais para animais de Jaguariúna, São Paulo, contando com uma equipe qualificada e... Cotar Agora Saiba Mais
 Clínica de Exame Laboratorial Veterinário
Clínica de Exame Laboratorial Veterinário
Clínica de Exame Laboratorial Veterinário
LABORATÓRIO CENTER VETO CenterVet é uma clínica de exame laboratorial veterinário especializada, com mais de duas décadas de experiência. Qualidades da clínica de exame... Cotar Agora Saiba Mais
 Clínica de Exame de Plaqueta Veterinária
Clínica de Exame de Plaqueta Veterinária
Clínica de Exame de Plaqueta Veterinária
LABORATÓRIO CENTER VETO CenterVet é uma clínica de exame de plaqueta veterinária. A análise de plaquetas é feita por meio do exame de sangue, no qual uma amostra do... Cotar Agora Saiba Mais
 Clínica de Exame de Leucograma Veterinária
Clínica de Exame de Leucograma Veterinária
Clínica de Exame de Leucograma Veterinária
LABORATÓRIO CENTER VETO CenterVet trabalha como clínica de exame de leucograma veterinária, uma análise de extrema autoridade para validar o estado geral de saúde de um... Cotar Agora Saiba Mais
Clínica de Exame de Laboratorial em Animais Silvestres
Clínica de Exame de Laboratorial em Animais Silvestres
Clínica de Exame de Laboratorial em Animais Silvestres
LABORATÓRIO CENTER VETO CenterVet é uma clínica de exame de laboratorial em animais silvestres, com patologistas especializados em todos os tipos de animais. O... Cotar Agora Saiba Mais
 Clínica de Exame de Laboratorial em Animais Exóticos
Clínica de Exame de Laboratorial em Animais Exóticos
Clínica de Exame de Laboratorial em Animais Exóticos
LABORATÓRIO CENTER VETO CenterVet é uma clínica de exame de laboratorial em animais exóticos, destinado ao atendimento especializado de proprietários de animais de... Cotar Agora Saiba Mais
 Clínica de Exame de Hemograma para Animais
Clínica de Exame de Hemograma para Animais
Clínica de Exame de Hemograma para Animais
LABORATÓRIO CENTER VETO CenterVet é uma clínica de exame de hemograma para animais de várias espécies, em especial para cães, gatos, aves e equinos. Competência em... Cotar Agora Saiba Mais
 Clínica de Exame de Hemograma Completo Veterinária
Clínica de Exame de Hemograma Completo Veterinária
Clínica de Exame de Hemograma Completo Veterinária
LABORATÓRIO CENTER VETO CenterVet atua como uma referência em clínica de exame de hemograma completo veterinária, para diagnósticos, tratamentos e acompanhamentos... Cotar Agora Saiba Mais
 Clínica de Exame de Fibrinogênio Veterinária
Clínica de Exame de Fibrinogênio Veterinária
Clínica de Exame de Fibrinogênio Veterinária
LABORATÓRIO CENTER VETO CenterVet é uma clínica de exame de fibrinogênio veterinária, cumprido para avaliar proteínas sintetizadas pelo fígado. O exame é feito por... Cotar Agora Saiba Mais
 Clínica de Exame de Antibiograma
Clínica de Exame de Antibiograma
Clínica de Exame de Antibiograma
LABORATÓRIO CENTER VETO CenterVet atua como clínica de exame de antibiograma, efetuado para análise da cultura de urina em animais de diversas espécies. A magnitude da... Cotar Agora Saiba Mais
 Clínicas Veterinárias
Clínicas Veterinárias
Clínicas Veterinárias
North PetSe deseja achar Clínicas Veterinárias, entre em contato com a North Pet, corporação conhecedora no segmento, com muitos anos de experiência não... Cotar Agora Saiba Mais
 Clínica Veterinária SP
Clínica Veterinária SP
Clínica Veterinária SP
North PetNa dúvida sobre qual Clínica Veterinária SP optar, escolha a North Pet, onde buscamos sempre prestar o melhor atendimento e serviços de... Cotar Agora Saiba Mais
 Clínica Veterinária na Zona Norte
Clínica Veterinária na Zona Norte
Clínica Veterinária na Zona Norte
North PetEstá querendo uma Clínica Veterinária na Zona Norte comprometida e eficiente para ajudar todas as suas necessidades e demandas? A North Pet pode... Cotar Agora Saiba Mais
 Clínica Veterinária em SP
Clínica Veterinária em SP
Clínica Veterinária em SP
North PetSe busca Clínica Veterinária em SP, não deixe de entrar em contato com a North Pet, opção ideal para quem busca economia, eficiência e... Cotar Agora Saiba Mais
 Clinica Veterinária em São Paulo
Clinica Veterinária em São Paulo
Clinica Veterinária em São Paulo
North PetSe busca Clinica Veterinária em São Paulo que ofereça o melhor preço em serviços e produtos de alta qualidade, não perca tempo e venha conhecer a... Cotar Agora Saiba Mais
 Clínica Veterinária em Santana
Clínica Veterinária em Santana
Clínica Veterinária em Santana
North PetEm dúvida sobre qual Clínica Veterinária em Santanaescolher? A North Pet é uma perfeita opção por contar com os mais empenhados profissionais do... Cotar Agora Saiba Mais
 Clínicas Veterinárias
Clínicas Veterinárias
Clínicas Veterinárias
North PetSe deseja achar Clínicas Veterinárias, entre em contato com a North Pet, corporação conhecedora no segmento, com muitos anos de experiência não... Cotar Agora Saiba Mais
 Clínica Veterinária SP
Clínica Veterinária SP
Clínica Veterinária SP
North PetNa dúvida sobre qual Clínica Veterinária SP optar, escolha a North Pet, onde buscamos sempre prestar o melhor atendimento e serviços de... Cotar Agora Saiba Mais
 Clínica Veterinária na Zona Norte
Clínica Veterinária na Zona Norte
Clínica Veterinária na Zona Norte
North PetEstá querendo uma Clínica Veterinária na Zona Norte comprometida e eficiente para ajudar todas as suas necessidades e demandas? A North Pet pode... Cotar Agora Saiba Mais
 Clínica Veterinária em SP
Clínica Veterinária em SP
Clínica Veterinária em SP
North PetSe busca Clínica Veterinária em SP, não deixe de entrar em contato com a North Pet, opção ideal para quem busca economia, eficiência e... Cotar Agora Saiba Mais
 Clinica Veterinária em São Paulo
Clinica Veterinária em São Paulo
Clinica Veterinária em São Paulo
North PetSe busca Clinica Veterinária em São Paulo que ofereça o melhor preço em serviços e produtos de alta qualidade, não perca tempo e venha conhecer a... Cotar Agora Saiba Mais
 Clínica Veterinária em Santana
Clínica Veterinária em Santana
Clínica Veterinária em Santana
North PetEm dúvida sobre qual Clínica Veterinária em Santanaescolher? A North Pet é uma perfeita opção por contar com os mais empenhados profissionais do... Cotar Agora Saiba Mais
 Veterinário para Gatos 24 Horas
Veterinário para Gatos 24 Horas
Veterinário para Gatos 24 Horas
PET SHOP E CLINICA VETERINARIA 24H QUERUBIMO Querubim Vet funciona como veterinário para gatos 24 horas, oferecendo tratamento especializado com base nas características dos felinos. Cada... Cotar Agora Saiba Mais
 Veterinário Emergência 24 Horas
Veterinário Emergência 24 Horas
Veterinário Emergência 24 Horas
PET SHOP E CLINICA VETERINARIA 24H QUERUBIMO Querubim Vet é um centro veterinário emergência 24 horas que reúne excelência e tratamento carinhoso no atendimento a cães, gatos e pets não... Cotar Agora Saiba Mais
 Veterinário 24h
Veterinário 24h
Veterinário 24h
PET SHOP E CLINICA VETERINARIA 24H QUERUBIMO Querubim Vet se destaca como centro veterinário 24h, voltado para consultas rotineiras e atendimentos emergenciais. A denominação de centro só é... Cotar Agora Saiba Mais
 Veterinário 24 Hr
Veterinário 24 Hr
Veterinário 24 Hr
PET SHOP E CLINICA VETERINARIA 24H QUERUBIMO Querubim Vet é um centro veterinário 24 hr que concede atendimento tanto rotineiro quanto para casos emergenciais. A estrutura de um centro... Cotar Agora Saiba Mais
 Veterinário 24 Horas Zona Sul
Veterinário 24 Horas Zona Sul
Veterinário 24 Horas Zona Sul
PET SHOP E CLINICA VETERINARIA 24H QUERUBIMO Querubim Vet é um centro veterinário 24 horas zona sul, capacitado para efetuar atendimento emergencial e de rotina. Nosso espaço está equipado... Cotar Agora Saiba Mais
 Veterinário 24 Horas Próximo
Veterinário 24 Horas Próximo
Veterinário 24 Horas Próximo
PET SHOP E CLINICA VETERINARIA 24H QUERUBIMO Querubim Vet funciona como centro veterinário 24 horas próximo a você. Com atendimento 100% presencial, baseado em excelência e carinho, temos... Cotar Agora Saiba Mais
 Veterinário 24 Horas Moema
Veterinário 24 Horas Moema
Veterinário 24 Horas Moema
PET SHOP E CLINICA VETERINARIA 24H QUERUBIMO Querubim Vet funciona como centro veterinário 24 horas Moema, atendendo a diferentes regiões da cidade de São Paulo. Enquanto centro veterinário,... Cotar Agora Saiba Mais
 Veterinário 24 Horas Mais Próximo
Veterinário 24 Horas Mais Próximo
Veterinário 24 Horas Mais Próximo
PET SHOP E CLINICA VETERINARIA 24H QUERUBIMO Querubim Vet é uma opção de veterinário 24 horas mais próximo de você, que se destaca pela característica dos serviços oferecidos. Deste jeito... Cotar Agora Saiba Mais
 Veterinário 24 Horas Atendimento Domiciliar
Veterinário 24 Horas Atendimento Domiciliar
Veterinário 24 Horas Atendimento Domiciliar
PET SHOP E CLINICA VETERINARIA 24H QUERUBIMO Querubim Vet é um centro veterinário 24 horas atendimento domiciliar. Receber o especialista veterinário em casa pode ser uma ótima opção para... Cotar Agora Saiba Mais
 Veterinário 24 Horas
Veterinário 24 Horas
Veterinário 24 Horas
PET SHOP E CLINICA VETERINARIA 24H QUERUBIMO Querubim Vet é um centro veterinário 24 horas que possui estrutura completa para solucionar demandas rotineiras e casos emergenciais. Oferecemos... Cotar Agora Saiba Mais
 Veterinário 24
Veterinário 24
Veterinário 24
PET SHOP E CLINICA VETERINARIA 24H QUERUBIMO Querubim Vet funciona como Centro Veterinário 24 horas com atendimento voltado para consultas rotineiras e casos urgentes. Os centros... Cotar Agora Saiba Mais
 Veterinária 24 Horas
Veterinária 24 Horas
Veterinária 24 Horas
PET SHOP E CLINICA VETERINARIA 24H QUERUBIMO Querubim Vet é um centro de veterinária 24 horas, com estrutura hospitalar completa. Em comparação às clínicas veterinárias, os centros se... Cotar Agora Saiba Mais
 Vacina Raiva Gato
Vacina Raiva Gato
Vacina Raiva Gato
PET SHOP E CLINICA VETERINARIA 24H QUERUBIMA vacina raiva gato do seu pet está em dia? Se está, muito bem! Caso contrário, o recomendado é que você vá a um centro veterinário, o Querubim Vet... Cotar Agora Saiba Mais
 Vacina para Gato Zona Sul
Vacina para Gato Zona Sul
Vacina para Gato Zona Sul
PET SHOP E CLINICA VETERINARIA 24H QUERUBIMBuscando vacina para gato zona sul? Diversas empresas atendem a área, como o Querubim Vet - Centro Veterinário 24 horas. Se você precisa de... Cotar Agora Saiba Mais
 Vacina para Gato Moema
Vacina para Gato Moema
Vacina para Gato Moema
PET SHOP E CLINICA VETERINARIA 24H QUERUBIMVacina para gato Moema? Conheça o Querubim Vet - Centro Veterinário 24 horas que atende a região. Afinal, é de suma autoridade que na escolha do... Cotar Agora Saiba Mais
 Vacina para Gato
Vacina para Gato
Vacina para Gato
PET SHOP E CLINICA VETERINARIA 24H QUERUBIMUm dos pontos mais importantes no cuidado dos pets é a vacina para gato. Com a vacinação, você protege o seu filhote de diversas doenças como... Cotar Agora Saiba Mais
Conheça mais sobre as outras paginas que podem lhe interessar : Clínica de Exames Laboratoriais para Pets , Clínica de Exame de Leucograma Veterinária e Clínica de Exame de Hemograma para Animais







